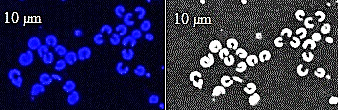

RobesのTwitterイラスト検索結果。 2,862 件中 129ページ目
old Hazen art vs. new Hazen art for comparison (look at the hem of his robes)
WangXian in GusuLan sect robes based on A-Xin’s design 🥰❄️ gonna turn this for self indulgent standee 💃 #modaozushi #魔道祖师
My DnD character, Portobello, is part of the cult of Robigus, god of Rust, Mushrooms and Peace.
Robigus imposes peace by destroying the weapons used for war. He is often depicted as a handsome human in red robes, a huge blood red snail, or a giant red myconid sovereign.
some of the stuff i've been working on that i'm happy with (especially that riskrunner and the warlock robes)
Do #microbes, which originate in our mouth, find their way to our intestine? Until now, this transfer was believed to be connected to a #disease. However, LCSB researchers recently showed, that this microbial exchange is also common among healthy people: https://t.co/GN1UrjYpfD
Just a little birthday art for @MrPorterhause5
I gotta say I like the way Shae looks in the Vampire Robes and some retro style stockings. What do you guys think?
alien merfolk totally count for #mermay ! working on concept art for undine fashion and art/architecture - obviously lots of ocean motifs, and bright colors and flowy cuts for undine wardrobes. Krie here is no exception!
#turningtidescomic #aliendesign #digitalillustration
6 mai 1758 Naissance à #Arras de Maximilien de #Robespierre. Avocat, député aux États Généraux, puis à la #Constituante et à la #Convention. Il est également membre du #Comité de Salut public du 27 juillet 1793 au 28 juillet 1794, date de son exécution à #Paris.
I was playing Gungeon and kept running into cute mages in my run, and I realized my favorite sort of character design is and has always been the black mages from Final Fantasy. Something about the flowing robes and what they could be packin under there... mmm....
Maximilien François Marie Isidore de Robespierre
言わずと知れたフランス革命で最も有名な革命家。世間一般(教科書)では未だに恐怖政治を断行した革命の狂信者&テロリスト扱いされている為、正当な評価をされる日が待たれる。崇拝者とアンチにハッキリ分かれる人物。
#Robespierre
My oc, Lexie, in the Jedi robes for Star Wars day
May the 4th be with you
Robespierre (6 May 1758 - 28 July 1794).
#Digital #DigitalArt #DigitalPortrait #FrenchRevolution #LaRévolutionFrançaise #ФранцузскаяРеволюция #Robespierre #MaximilienRobespierre #Робеспьер #Thermidor #France #History #FrenchHistory #HistoiredeFrance #Histoire #18thcentury
@FizzyDog_ Spectrobes is a fav of mine for this kind of faux-pokemon style
Varys, Lord of Whispers is up!
I could think of no cat breed better suited for him...but I did give him his robes too.
#GameofThrones #got #Varys #fanart #DemThrones
Tried a new sketch and color design with this piece of Jeena from Spectrobes. Personally, I am very happy with it visually ^^
#Spectrobes #Jeena
Day 953: Wizard Robe! Tonight's result didn't work out. It really wasn't coming together, and I think I got the proportions wrong. Still, I do wanna get better at drawing robes since I have some harry potter pictures I want to draw. I'll just have to keep practicing to get it!
I would love to draw my #oc Noemi in some different looks, she'll look good in anything! Please send me your wardrobes!